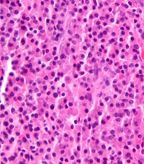

ARRY-520, a novel selective kinesin spindle protein (KSP) inhibitor showed promising clinical activity both alone and combined with low-dose dexamethasone in a phase II clinical trial in patients with relapsed and refractory multiple myeloma.
ARRY-520, a novel selective kinesin spindle protein (KSP) inhibitor, showed promising clinical activity both alone and combined with low-dose dexamethasone in a phase II clinical trial in patients with relapsed and refractory multiple myeloma. Findings were reported by Jatin J. Shah, MD, of the department of lymphoma/myeloma at the University of Texas MD Anderson Cancer Center in Houston.
Micrograph of a plasmacytoma, H&E stain; source: Nephron, Wikimedia Commons
ARRY-520 specifically inhibits KSP (kinesin-5 or Eg5), resulting in activation of the spindle assembly checkpoint, induction of cell cycle arrest during the mitotic phase, and apoptosis in actively dividing tumor cells. Because KSP is not involved in postmitotic processes (ie, neuronal transport), ARRY-520 does not cause the peripheral neuropathy often associated with tubulin-targeting agents.
Each of the two cohorts in the present study were designed as a two-stage single-arm phase II study. Cohort 1 evaluated the efficacy and safety of 1.5 mg/m2/d ARRY-520 administered intravenously on days 1 and 2 every 2 weeks with prophylactic granulocyte colony-stimulating factor (G-CSF) support. Eligible patients had relapsed or refractory multiple myeloma with two prior lines of therapy that included both bortezomib and an immunomodulatory agent (IMiD). Cohort 2 evaluated the efficacy and safety of the same dose and schedule of ARRY-520 and G-CSF with 40 mg dexamethasone administered orally weekly. Eligible patients had relapsed and refractory multiple myeloma with two prior lines of therapy, and had disease refractory to (progressed on or prior to 60 days of treatment) their last line of therapy and that was refractory to bortezomib, lenalidomide, and dexamethasone.
At the time of data cutoff, 32 patients were enrolled in cohort 1 with a median age of 65 years (range 51–82) and a median of 6 prior regimens (range 2–19). All patients had received prior IMiD, 90% received prior bortezomib and 78% had prior autologous stem cell transplant. Eighteen evaluable patients were enrolled in the defined first stage of cohort 2, with a median age of 67 years (range 53–78) and a median of 10 prior therapies (range 5–13).
Safety was similar for both cohorts. The most commonly reported (20% of patients) treatment-related adverse events in both cohorts included thrombocytopenia, anemia, neutropenia, and fatigue. No treatment-related events of neuropathy were observed in either cohort. Treatment discontinuations due to adverse events were infrequent (9%, 11%).
Of 32 patients in cohort 1, confirmed responses (greater than or equal to minor response) were observed in 6 patients (19%), and partial responses were observed in 5 patients (16%). Median treatment time was 2.1 months. In the subset of patients with disease refractory both to bortezomib and lenalidomide, a 15% overall response rate (ORR) greater than or equal to minor response was observed.
Among the 18 patients in cohort 2 with triple-refractory multiple myeloma and a median number of 10 prior treatment regimens, the combination of ARRY-520 plus low-dose dexamethasone demonstrated a 22% ORR greater-than or equal to partial response, and manageable safety. The most common drug-related adverse events include myelosuppression, fatigue, and mucosal inflammation. At the time of data cutoff, median treatment time was 3.9 months.
“These data are comparable to those reported for pomalidomide or carfilzomib in less heavily pretreated patients,” noted Dr. Shah. “Both the median time on study and ORR in cohort 2 were greater than the activity seen for cohort 1, despite the more advanced stage of these patients and the fact that they were heavily pretreated with dexamethasone, suggesting that low-dose dexamethasone may enhance ARRY-520 activity.”
The investigators noted that patients with relapsed multiple myeloma refractory to both IMiD and proteasome inhibitor therapy have a poor prognosis with median survival of as little as 6 months. Thus, new drugs with clinically meaningful activity in this population are needed.
“ARRY-520 is a novel agent with a distinct mechanism of action relative to other myeloma drugs and shows promising clinical activity both alone and combined with dexamethasone in relapsed and refractory MM. Based on this evidence of activity, further development of ARRY-520 plus low-dose dexamethasone is warranted in patients who have exhausted other therapeutic options.”
"ARRY-520 is a first-in class drug in myeloma with a novel mechanism of action that is very well tolerated and importantly shows very encouraging clinical activity in heavily pretreated patients who have limited therapeutic options,” said Dr. Shah.
ARRY-520 is being developed by Array BioPharma Inc, Boulder, Colorado.
Navigating AE Management for Cellular Therapy Across Hematologic Cancers
A panel of clinical pharmacists discussed strategies for mitigating toxicities across different multiple myeloma, lymphoma, and leukemia populations.